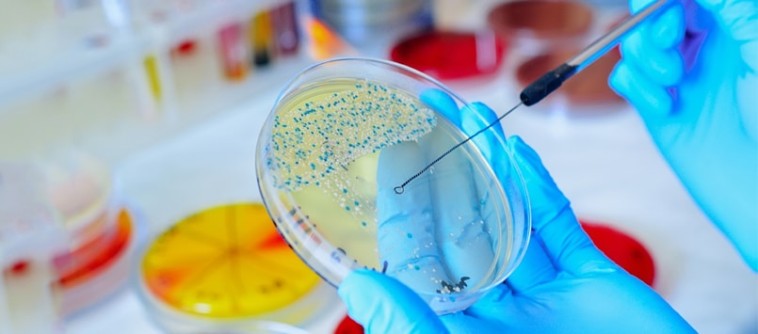

Microbiology and Infectious Diseases
Contact Expert
See profile
See profile
See profile
See profile
The Department of Microbiology and microbial genetics specializes in the detection and diagnosis of infectious diseases in the field of bacteriology, parasitology virology and mycology.
The department provides accurate results on clinical material within the shortest possible time. With the use of state-of-the-art equipment the department carries out full range of high quality microbiology services, from routine cultures to molecular diagnostic testing.
The primary role of a microbiology and microbial genetics laboratory in patient care is to aid clinicians in identifying causative agents of various infectious diseases and help determine the antimicrobial susceptibility profiles, detection of multi-resistant bacteria, when appropriate. The information provided by the microbiology and microbial genetics laboratory enables the clinicians to initiate or modify therapy, which will have a direct impact on patient outcome.
In order for microbiology to aid in diagnosing the correct infectious disease, a number of steps occur. The first step is the collection of the appropriate specimens to diagnose the patient's disease. Specimens may be collected from a number of different sources, including blood, urine, and swab specimens. Sometimes a more invasive technique using a needle or other special instrument is required to collect the specimen. This first step in microbiology diagnosis of infectious disease is very important! A good quality specimen means the best chance of diagnosing the infectious disease.
After the collection of the specimen and input from the physician about what the possible infectious disease may be, the laboratory decides what technique is best to identify the infectious disease and the organism likely causing the problem. All of the techniques look for some product of an organism. The time it takes to identify the organism is dependent on the technique used, as well as how complicated the testing process may be. For the patient, this means the lab may be able to provide an answer in anywhere from 15 minutes to eight weeks!
Microbiology lab
The Clinical Microbiology Laboratory is a full-service laboratory offering diagnostic bacteriology, mycology, Parasitology and mycobacteriology. The Laboratory is staffed with experienced technologists and microbiologists
Bacteriology
We Isolate and identify clinically significant microorganisms from clinical specimens and perform antimicrobial susceptibility testing according to the latest international standards .
Performs blood cultures using the Bactec system, which provides continuous monitoring of blood cultures for the entire 7-day incubation period.
The Mycology Section
Performs identification of clinically significant yeast isolates. Provides identification of pathogenic moulds recovered from clinical specimens, including dermatophytes.
The Parasitology Section
Provides services for the diagnosis of various parasitic infections; Specimens submitted for parasitology include.
Stool specimens for the detection of pathogenic amoebae, and flagellates, and for detection/identification of the ova belonging to various nematode (roundworms), cestode (tapeworms), and trematode (flukes) species.
Blood specimens are also submitted for the diagnosis and species identification of malarial and microfilariae parasites.
mycobacteriology: Isolation of M. tuberculosis from various clinical samples and performance of sensitivity testing.
Others: urine, Gynecological swabs, Tissues...etc depending on the suspected infection.
Microbial Genetics
Hepatitis B Virus
Is one of several viruses known to cause viral hepatitis. Chronic carriers are at high risk of long term complications of infection, including chronic hepatitis, cirrhosis, and hepatocellular carcinoma. Quantitation of HBV viral DNA is a reliable method to measure the viral replication of virus, and for monitoring the response to therapy.
Methodology
Is based on Real-Time Polymerase Chain Reaction PCR. This includes DNA processing, amplifying and simultaneously detecting using fluorescent reporter dye probes.
Hepatitis C Virus
Is considered to be the principle agent responsible for 90-95% of the cases of post-transfusion non-A and non-B hepatitis. Detection and quantitation of HCV RNA offer a measure of active viremia. It makes it possible to detect changes in the viral load in antibody-positive chronic HCV infected patients undergoing therapy with interferon.
Methodology
Is based on isolation of HCV RNA, RNA - reverse transcription and Real-Time Polymerase Chain Reaction PCR (amplifying and simultaneously detecting using fluorescent reporter dye probes).
Sexually Transmitted Diseases (STDs)
Represent a group of diseases that affect the sexual and reproductive health of millions of people, being a public problem of interest. Etiological agents responsible for STDs include fungi, bacteria, parasites and viruses. Some of these microorganisms are eliminated after a period of time, while others are recurrent and some remain in the body asymptomatically, allowing the progress of the disease and generating consequences such as inflammations of the genito-urinary tract, infertility and even the development of cancer.
The panel includes; Neisseria gonorrhoeae, Chlamydia trachomatis, Mycoplasma genitalium, Treponema pallidum and herpes simplex virus types 1 or 2 (HSV-1/ 2)
Methodology
Is based on Real-Time Polymerase Chain Reaction PCR. This includes DNA processing, amplifying and simultaneously detecting using fluorescent reporter dye probes.
Human Papillomavirus (HPV)
Is responsible for a variety of skin and mucosa disorders. The clinical manifestations may vary according to the anatomic location of the lesion and the type of HPV involved.
The anogenital HPVs are generally divided into two categories: those with a low oncogenic potential risk (Low-Risk Group) and those with a high oncogenic potential risk (High-Risk Group). The high-risk HPVs are generally associated with high-grade precancerous lesions and invasive cancer, while low-risk HPVs are frequently found in asymptomatic or benign conditions such as genital warts.
Methodology
Is based on the principle of reverse hybridization and allows qualitative detection and identification of 37 genital HPVs (Low and High risk genotypes) in DNA samples from cervico-uterine smears or biopsies.
Mycobacterium Tuberculosis
For the detection and diagnosis of M. tuberculosis.
Methodology
Is based on Real-Time Polymerase Chain Reaction PCR. This includes DNA processing, amplifying and simultaneously detecting using fluorescent reporter dye probes.
Fast syndromic diagnostic testing
helps the healthcare providers to deliver efficient and timely patient centered care. It greatly reduces diagnostic uncertainty, and helps overcome mistakes and inefficiencies that commonly result from testing one or few organisms at a time.
Testing multiple pathogens in a single test reaction is known as multiplexing. Multiplex molecular syndromic testing gives answers that are more accurate, comprehensive, and actionable for real-life decisions in critical care. Current technologies offer the potential to have a definitive diagnosis in about 1 hour, allowing timely decisions about treatment, hospital admission, and infection.
Now available is the QIAstat-Dx Respiratory and Gastrointestinal Panel.
Respiratory pathogens Panel
Is a qualitative test to analyze 20 targets for common pathogens causing acute respiratory tract infections. This panel utilizes powerful QIAGEN sample and assay technologies, to deliver a true Sample to Insight solution.
18 viruses : Adenovirus,Bocavirus,Coronaviruses (229E,HKU1,NL63,OC43),Human metapnemovirus A/B, Influenza viruses ( A,Subtype H1N12009,Subtype H1,Subtype H3,B), Parainfluenza viruses ( 1,2,3,4), Respiratory syncytial virus A/B,Rhinovirus,Enterovirus.
3 bacteria: Bordetella pertussis,Legionella Pneumophilia,Mycoplasma pneumoniae.
Gastrointestinal pathogens Panel
Includes the most common viral, bacterial and parasitic pathogens that cause gastrointestinal infections, and that generally present with nearly indistinguishable signs and symptoms.
The rapid and accurate knowledge of the presence or absence of the causative agents help make timely decisions about hospital admission, treatment, infection control, and patient return to work and family. It furthermore may greatly support antimicrobial stewardship and other important public health initiatives.
14 Bacteria: Clostridium difficile toxin A/B, E.coli (Enterotoxigenic E. coli (ETEC) Enteropathogenic E. coli (EPEC),Enteroinvasive E. coli (EIEC)Enteroaggregative E. coli (EAEC) Shiga like toxin producing E.coli,), Pathogenic Campylobacter spp.( C. jejuni (subspecies jejuni) C. coli.,C. upsaliensis),Plesiomonas Shigelloids,Salmonella,Vibrio Spp.( cholera), V. parahaemolyticus, and V. vulnificus. ) , Yersinia enterocolitica.
4 Parasites: Cyclospora cayetanensis,Cryptosporidium,Entamoeba histolytica,Giardia lambia.
6 Viruses: Adenovirus,Astrovirus,Norvirus (GI, GII),Rotavirus A,Sapovirus (I,II,IV,V).
For further information, please contact:
- Rand Shwayhat, Head of Routine and microbiology departments, r.shwayhat@biolab.jo
- Nour Awamleh, Geneticists, n.awamleh@biolab.jo
- Lina Mohammad , Lab Director, l.mohammad@biolab.jo
Copyright © biolab 2026, Developed by Tech Factory